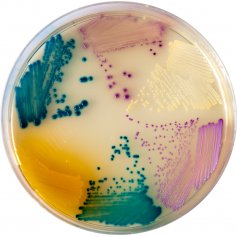

潘高輝,毛彩萍
(浙江省腫瘤醫(yī)院,浙江杭州 310022)
【關鍵詞】 定位顯色;培養(yǎng)基;應用評價
【中圖分類號】R378 【文獻標識碼】B
尿道感染為臨床常見的感染性疾病之一,快速而準確的鑒定出病原菌并給予準確的藥敏結果才能正確治療。傳統(tǒng)細菌培養(yǎng)法程序繁瑣,常常不能及時鑒定出病原菌以致延誤診斷。筆者用科瑪嘉尿道定位培養(yǎng)基,取得了較好的結果。
1 材料與方法
1. 1 標本來源 浙江省腫瘤醫(yī)院2004年6月~2005年7月門診及住院患者經無菌操作留取的642份中段尿標本,立即送檢。
1. 2 干粉培養(yǎng)基 科瑪嘉尿道定位培養(yǎng)基,麥康凱瓊脂,血瓊脂。
1. 3 其他材料 VITEK-32微生物鑒定儀及GPI、GNI+鑒定卡為生物梅里埃產品,微量生化管為杭州天和微生物試劑有限公司產品。
1. 4 培養(yǎng)方法 收集的臨床標本用定量接種環(huán)分別接種血平板、麥康凱平板和科瑪嘉尿道定位培養(yǎng)基, 37℃培養(yǎng)24 h觀察結果,記錄菌落生長顏色并用生化微量管和(或)VITEK-32進行鑒定。
2 結果
642份臨床標本中有287份培養(yǎng)陽性,并對這些陽性標本分別用傳統(tǒng)方法和尿道菌定向培養(yǎng)法鑒定細菌,鑒定結果見
表1。
表1 287例尿液陽性標本分離鑒定和菌落顏色變化
菌種 傳統(tǒng)鑒定 尿道定位顯色 顏色
大腸埃希菌 165 165 粉紅色
腸球菌屬 32 32 藍綠色,較淺
肺炎克雷伯菌 20 20 藍綠色,較深,有粘性
表皮葡萄球菌 25 25 白色至淡黃色
弗氏枸掾酸鹽復合菌 6 6 藍色
腸桿菌屬 8 8 翠綠色
變形桿菌屬 5 5 褐色,有遷徒現象
白色念珠菌 8 8 乳白色
不動桿菌屬 4 4 乳白色
銅綠假單胞菌 4 4 咖啡色,有金屬光澤
金黃色葡萄球菌 3 3 金黃色,較小
少動鞘氨醇單胞菌 3 3 奶油色,半透明
鏈球菌屬 2 2 天藍色
嗜麥芽寡糖養(yǎng)單胞菌 1 1 奶油色,半透明
粘質沙雷菌 1 1 墨綠色
3 討論
通過科瑪嘉尿道定位顯色培養(yǎng)基與血平板的平行對照實驗方法,對臨床收集的中段尿標本進行分離培養(yǎng)和鑒定,結果顯示2種培養(yǎng)基的檢出率差異無顯著性,其靈敏度和特異性基本一致。檢測結果顯示,引起尿道感染的主要致病菌為大腸埃希
菌(57.5%)、腸球菌屬(11.2%)、表皮葡萄球菌(8.7%)、肺炎克雷伯菌(7.0%)等。由于大腸埃希菌在定位培養(yǎng)基上呈現出明顯的粉紅色,顏色特異,極易辨認,因此培養(yǎng)基允許用吲哚試驗來鑒定大腸埃希菌;常見的腸球菌尤其是糞腸球菌在定位培養(yǎng)基上呈清晰、細小的藍綠色,在定位培養(yǎng)基上呈現滲入性生長,一目了然,結合血平板上的菌落特征,可以作出尿道感染的快速診斷;銅綠假單胞菌、金黃色葡萄球菌、變形桿菌等細菌生長特有的色素或粘性在定位培養(yǎng)基上都能顯現,僅需要進行幾個目的生化試驗即可明確結果,特別是變形桿菌,可以在尿道定位培養(yǎng)基上使用苯丙氨酸試驗(Fed3)來鑒定;但對于不動桿菌屬、沙雷菌屬、凝固酶陰性葡萄球菌、腸桿菌屬等少見感染菌的鑒定不是很理想,因為這些菌具有相似的菌落形態(tài)與顯色,尚需要進一步的生化試驗來確定。傳統(tǒng)的鑒定方法常需要麥康凱和血平板進行互補,只能區(qū)別乳糖陽性和乳糖陰性,很難區(qū)分是否有混合感染。尿道定位顯色不僅顯示快速,對于占尿道感染菌的60%~70%的大腸埃希菌和腸球菌可以直接準確鑒定,減少培養(yǎng)后所需要的生化鑒定試劑及工作量。由于定位培養(yǎng)基上不同的細菌僅菌落本身呈現特定的顏色,菌落周圍培養(yǎng)基并不著色,很容易從混合感染標本中辨認出2種或2種以上的目標菌,不易漏檢,且顯色的菌落不影響生化鑒定。鑒于定位培養(yǎng)基上菌落產生特定顏色的原理是在培養(yǎng)基中加入檢測某些菌中特異性酶的底物,因而此培養(yǎng)基也可以用來鑒定其它感染區(qū)域例如創(chuàng)傷、燒傷以及胸腹水等部位不同的微生物。
總而言之,使用尿道定位培養(yǎng)基做尿道病原菌的分離和鑒定具有直觀和易于鑒定的特點,可簡化鑒定程序,大大提高實驗室的檢測效率,有助于泌尿道感染的快速診斷,值得推廣應用。
